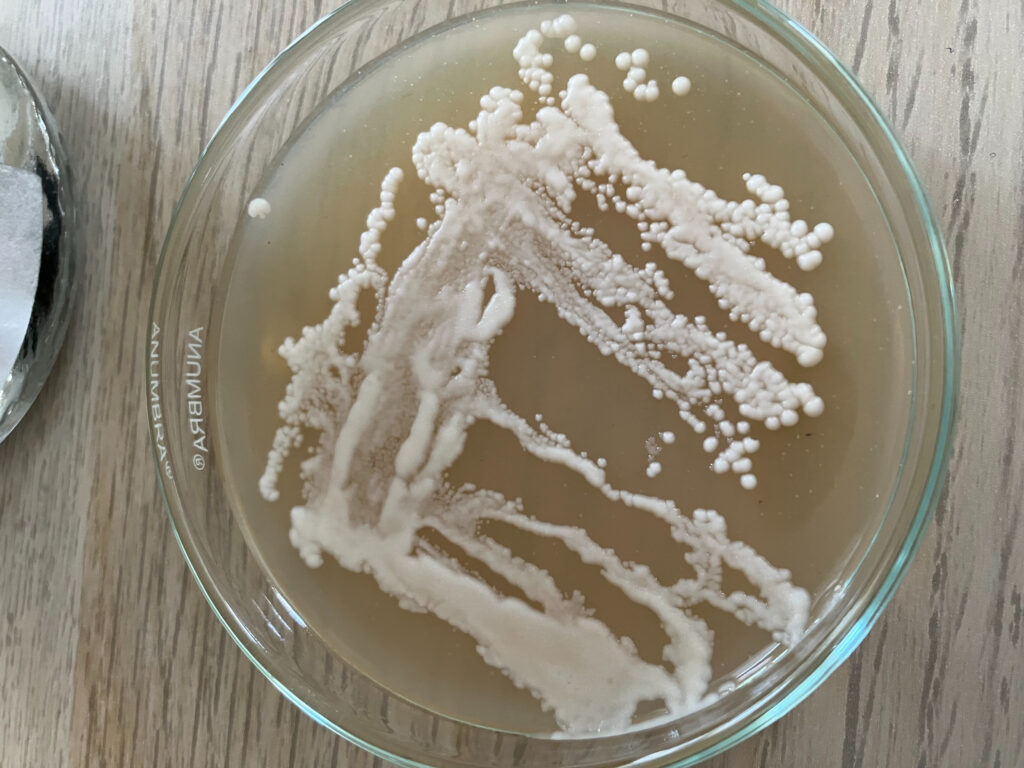

L’Invisible au Pouvoir : Voyage au cœur du laboratoire
Si le houblon a été mon premier coup de foudre de brasseur, la levure est devenue mon obsession secrète. Bienvenue dans l’univers de l’infiniment petit, là où se joue réellement l’âme de la bière. Suivez-moi dans mon laboratoire, entre boîtes de Petri et éprouvettes, à la poursuite des ferments sauvages qui feront les signatures Houblonium […]
